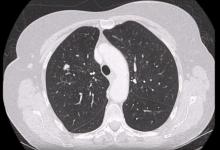

Four Cases of Redo Lung Surgery by VATS [1]
The authors present a video demonstrating redo lung resection by VATS to show that previous surgery on the thorax does not contraindicate a minimally invasive re-intervention. The literature on this topic currently consists of case reports and small case series. Although there is little in the literature on this subject, D’Amico and colleagues do not list redo surgery within the contraindications for VATS. The authors’ experiences confirm this. This video shows four lung resection procedures, highlighting specific techniques for the treatment of the different pathologies.
The authors conclude that not only is a previous cardiothoracic procedure not a contraindication for lung resection by VATS, but the magnification and angle of the optic can better show adhesions, especially at the apex and in the costophrenic recess, resulting in a safer dissection technique. Additionally, a thoracotomy could be harmful in these cases where the lung is tightly adherent to the parietal pleura.
Suggested Reading
Hanna JM, Berry MF, D’Amico TA. Contraindications of video-assisted thoracoscopic surgical lobectomy and determinants of conversion to open. J Thorac Dis. 2013 Aug;5 Suppl 3:S182-189. [3]
This video was previously presented at the 2017 Scandinavian Society for Research in Cardiothoracic Surgery Annual Meeting.